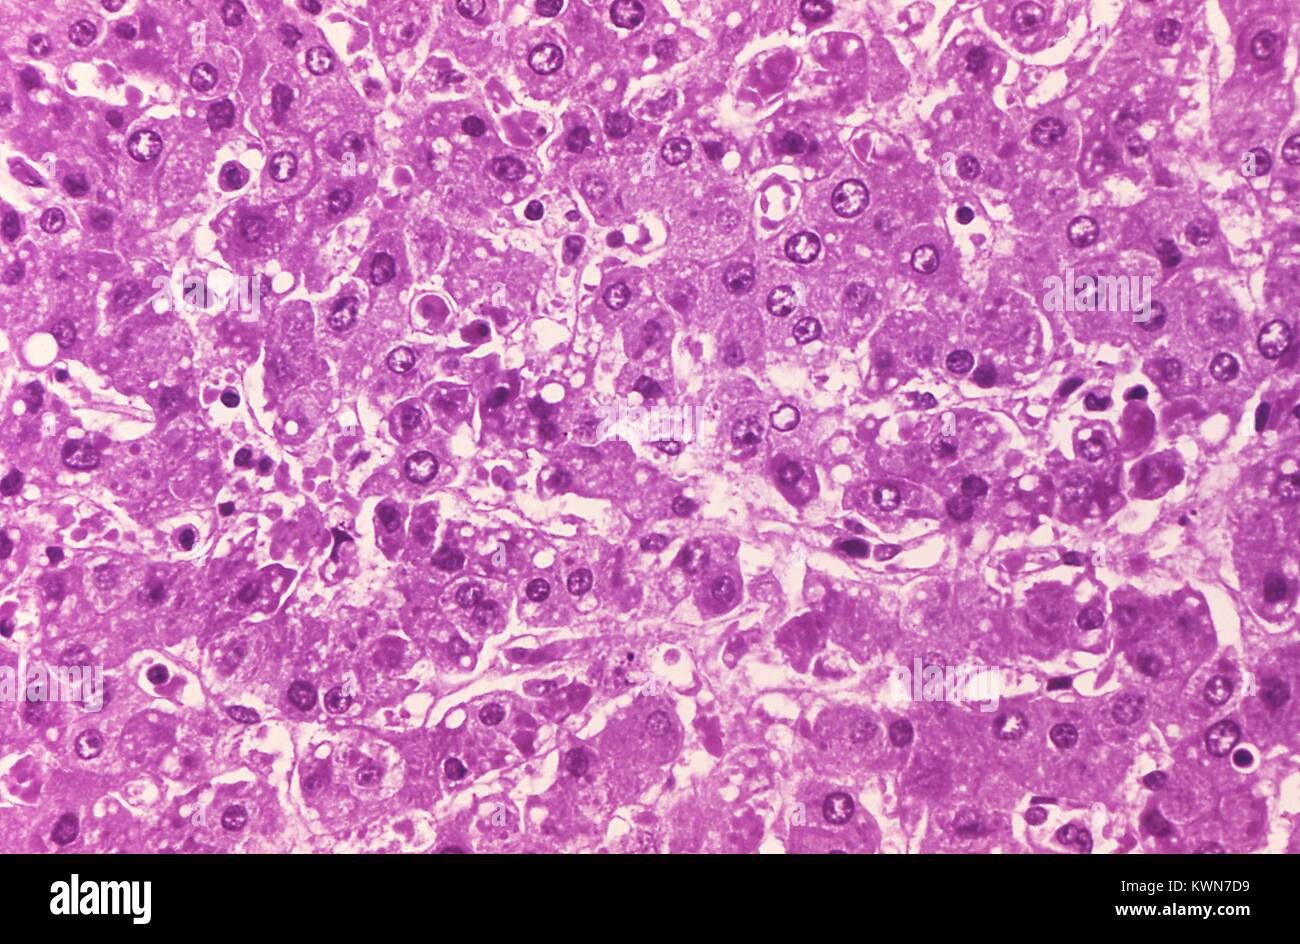

Пятнистый некроз
Пятнистый некроз 101 фото
Торговое помещение с отдельным входом
Клевер луговой двудольный или
Работа грузчиком свежие вакансии красноярск
Помощь правительства бизнесу
Американские мягкие игрушки
0xc0000005 call of duty
Примеры способов подбора
Кристалл кар москва
Заржавела цепь на велосипеде
Оливки с вином